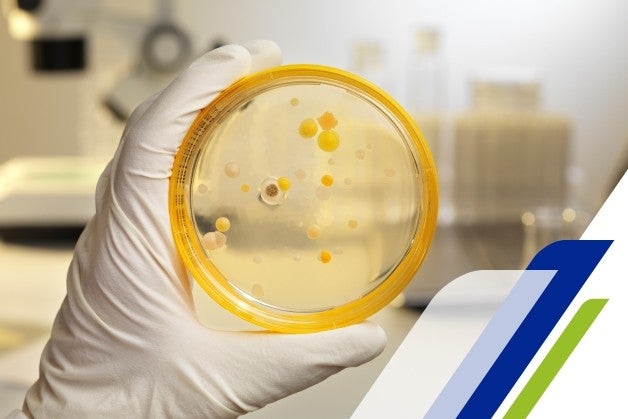

Assim funciona a tecnologia de Protex
Protex vai além da limpeza básica. Enquanto os sabonetes comuns eliminam as bactérias, o sabonete Protex oferece uma proteção superior graças à sua tecnologia Promega 3, eliminando 99,9% das bactérias* e fortalecendo a barreira protetora da sua pele por até 12 horas**.
Como isso é possível? A tecnologia Promega 3 fortalece as defesas naturais da sua pele, ajudando você a mantê-la protegida por mais tempo.
*Bactérias e vírus eliminados: E. Coli, S. aureus, P. aeruginosa e os vírus SARS-Cov2 e Influenza A(H1N1).
**Após 2 semanas de uso diário, o peptídeo antimicrobiano aumenta vs. sabonete em barra comum do mesmo fabricante.